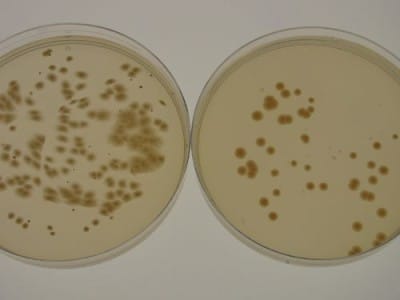
Ученые создали обувь из бактерий

Компания Modern Synthesis начала производство обуви из наноцеллюлозы, которая вырабатывается бактериями Komagataeibacter rhaeticus. Разработчики считают, что созданная таким образом модель станет достойной альтернативой кроссовкам животного и нефтехимического происхождения. Для создания такой продукции двумерный каркас из пряжи погружают в ферментационную среду из бактерий, производящих целлюлозу.
Komagataeibacter rhaeticus плетут ткань кроссовок поверх каркаса. После изготовления кроссовок их стерилизуют и вымывают бактерии. Чтобы у этой обуви был шанс конкурировать на рынке, Modern Synthesis работает над созданием мультигенных систем в бактериях с высоким содержанием целлюлозы, что добавит прочность и стабильность покрытию, пишет 4pda.to.
Отмечается, что компания Modern Synthesis уже ведет переговоры с несколькими производителями спортивной одежды.